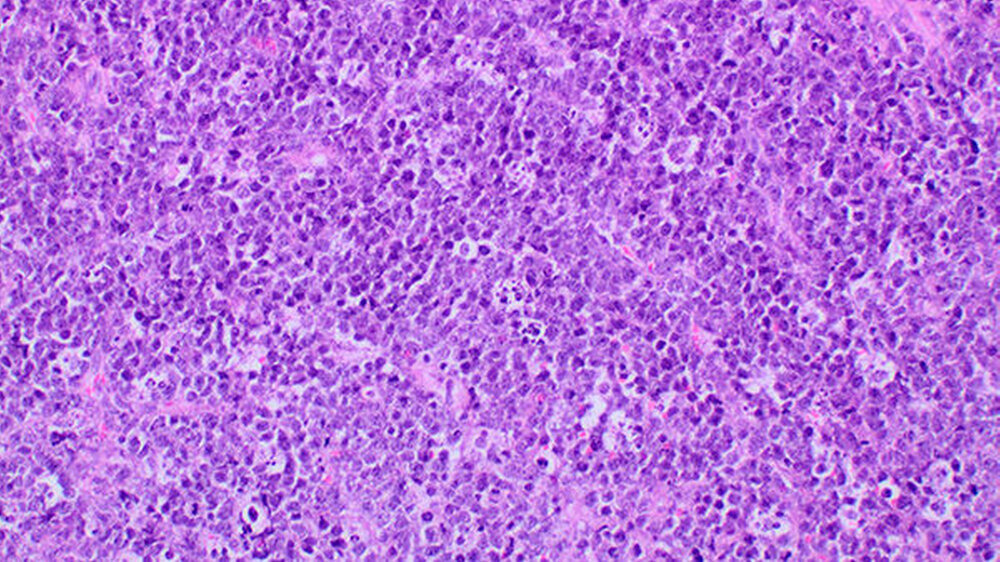

Burkitt-Lymphom bei einem Siebenjährigen
Ein siebenjähriger, aus dem Irak stammender Patient wurde von seinen Eltern mit progredienter Schwellung der linken Wange unter der Verdachtsdiagnose eines dentogenen Abszesses in der interdisziplinären Notaufnahme des Klinikums Nürnberg vorgestellt.
Anamnese
Die Anamnese war aufgrund der Sprachbarriere erschwert, es hieß seitens der Eltern, der Zustand bestünde schon seit einigen Tagen. Es wurden keine Vorerkrankungen und keine feste Medikation angegeben. Die klinische Untersuchung zeigte eine weiche, wenig schmerzhafte Schwellung im linken Oberkiefervestibulum (Abbildung 1).
Die Zähne 64, 65 und 75 waren kariös zerstört. Weiterhin wurden bei der eingehenden Untersuchung zweit- bis drittgradige Lockerungen an sämtlichen Milchmolaren des Oberkiefers, zweitgradige Lockerungen der Milchmolaren im Unterkiefer sowie erst- bis zweitgradige Lockerungen der bleibenden Inzisivi am Oberkiefer festgestellt.
Die Mundschleimhaut war intakt, die Sensibilität im Gesichtsbereich und die Mundöffnung mit 33 mm Schneidkantendistanz waren unauffällig. Zervikal konnten beidseits mehrere vergrößerte Lymphknoten palpiert werden, die übrige körperliche Untersuchung zeigte keine Auffälligkeiten. Die laborchemischen Entzündungsparameter (Leukozyten, CRP) waren im Normbereich.
Diagnostik
Da sich somit Zweifel an der Verdachtsdiagnose eines Abszesses ergaben, wurde eine weiterführende Diagnostik eingeleitet. Hierbei ergab sich ein unauffälliges Differentialblutbild. Die Werte für Parathormon und alkalische Phosphatase lagen im Normbereich. Jedoch fand sich eine starke Erhöhung der Laktatdehydrogenase (LDH) auf 807 U/l (Norm: 120 - 300 U/l).
Da die konventionelle Röntgenuntersuchung keinen wegweisenden Befund zeigte, wurde die bildgebende Diagnostik um eine Dünnschicht-Computertomografie (HR-CT) des Mittelgesichts, eine Magnetresonanztomografie (MRT) des Kopf-Hals-Bereichs und eine Halssonografie erweitert.
In der HR-CT zeigten sich Arrosionen am Oberkiefer und Kieferhöhlenboden sowie eine irreguläre Knochenbinnenstruktur mit Rarefizierung der Kochentrabekel und Demineralisation im Mittelgesichtsbereich, weiterhin eine Verschattung der Kieferhöhlen beidseits (Abbildungen 2 und 3).
Sonografisch fielen multiple pathologisch vergrößerte Lymphknoten am Hals beidseits auf. Dies bestätigte sich in der MRT, welche darüber hinaus eine Infiltration von Ober- und Unterkiefer, Schläfen- und Keilbein mit ossärer Destruktion und Knochen überschreitender Weichteilkomponente aufwies (Abbildung 4). Weitere Herde wurden im Schulterblatt, am Humerus-Kopf, sowie im Schlüsselbein, und an den Halswirbeln festgestellt.
Histopathologie und Diagnosestellung
Bei nunmehr nachgewiesenem multisystemischen Befall erfolgte die Gewinnung einer Gewebeprobe aus der Raumforderung des Oberkiefervestibulums, in deren Rahmen auch die kariösen Zähne entfernt wurden. Klinisch fand sich graues Gewebe von fischfleischartiger Konsistenz. Histologisch zeigte sich ein rasenförmiges Infiltrat mittelgroßer blastärer Zellen mit zahlreichen Mitosefiguren und „sternhimmelartig“ eingestreuten Makrophagen (Abbildung 5).
Der immunhistochemische Nachweis einer positiven Reaktion auf CD20 und c-myc (Abbildung 6) sowie die hohe Proliferationsfraktion (MIB-1) von über 90 Prozent führten zur Diagnose eines aggressiven Non-Hodgkin-Lymphoms der B-Zell-Reihe.
Durch in situ Hybridisierung wurde eine Expression des Epstein-Barr-Virus (EBV) ausgeschlossen. Somit konnte in der Zusammenschau aller Befunde die Diagnose eines Burkitt-Lymphoms gestellt werden. Der Patient wurde zur Induktion einer Chemotherapie in eine kinderonkologische Klinik verlegt.
Diskussion
Unterschieden wird zwischen der endemischen, sporadischen und der HIV-assoziierten Form des Burkitt-Lymphoms. Differenzialdiagnostisch muss das diffuse großzellige B-Zell Lymphom abgegrenzt werden. Die endemische Form des Burkitt-Lymphoms (zum Beispiel in Äquatorialafrika) ist in 95 Prozent der Fälle mit einer Infektion durch das Epstein-Barr-Virus assoziiert [Herold, et al., 2006].
Die Lokalisation im Ober- und Unterkieferknochen sowie das Auftreten im Kindes- und Jugendalter sind typisch. Bei der sporadischen, in Europa und Nordamerika auftretenden Form hingegen ist eine EBV-Assoziation nur in 20 Prozent der Fälle nachzuweisen und die Erkrankung manifestiert sich vornehmlich in abdominellen Lymphknoten.
In Deutschland stellen Burkitt-Lymphome einen Anteil von 4 Prozent aller Non-Hodgkin-Lymphome dar. Beim erwachsenen Patienten ist die Erkrankung häufig mit einer Infektion mit dem Humanen Immundefizienz-Virus (HIV) vergesellschaftet.
Auf molekulargenetischer Ebene liegt in 80 Prozent der Fälle eine Translokation von Chromosom 8 auf Chromosom 14 zugrunde [Herold, et al., 2006]. Dadurch gerät das c-myc-Gen, das als Transkriptionsfaktor eine wichtige Rolle bei der Steuerung der Zellteilung inne hat, unter den Einfluss von Promotern der Immunoglobulin-Gene.
Da diese Gene laufend transkribiert werden, kommt es zu einer Überexpression von c-myc und damit zur Entartung der Zelle. Durch weitere Transformationsprozesse wie beispielsweise einem Rearrangement der Immunglobulin-Gene wird der Apoptose-Mechanismus gestört, und es kommt zur monoklonalen Proliferation.
Therapie
Die Therapie orientiert sich an der für akute lymphatische Leukämien und richtet sich nach dem Krankheitsstadium. Prognostisch ungünstig sind dabei eine Erhöhung des LDH-Werts im Plasma auf mehr als 500 U/l und der Befall des zentralen Nervensystems (ZNS).
Standardtherapie ist eine systemische Hochdosis-Chemotherapie mit intrathekaler Chemoprophylaxe beziehungsweise -therapie [Woessmann et al, 2005; Cairo, et al., 2007]. Eine Bestrahlung kommt nur im Falle von Rezidiven oder bei manifestem ZNS-Befall in Betracht [Salzburg et al., 2007].
Eine chirurgische Intervention dient lediglich zur histologischen Sicherung und darf nur im Ausnahmefall bei risikolos und vollständig resektablen Befunden in therapeutischer Absicht erfolgen [S1-LeitlinieNon-Hodgkin-Lymphome, 2009].
Der zusätzliche Einsatz monoklonaler Antikörper wie das gegen CD20 gerichtete Präparat Rituximab eröffnet auch im Kindes- und Jugendalter neue Therapieoptionen [Giulino-Roth, et al., 2016]. Im Falle der Therapierefraktärität besteht die Option einer myeloablativen Chemotherapie mit konsekutiver autologer Stammzelltransplantation.
Fazit für die Praxis
Bei Zahnlockerungen unklarer Genese müssen Knochenneubildungen oder systemische Erkrankungen als Ursache ausgeschlossen werden. Schwellungen müssen nicht immer entzündlich bedingt sein und können ebenfalls Malignome maskieren.
Eine weiterführende bildgebende Diagnostik, die histopathologische Untersuchung sowie eine laborchemische Analyse sind in diesen Fällen obligat.
Um eine schnelle Behandlung mit eventueller Kuration zu ermöglichen, empfiehlt sich eine sofortige Überleitung von Patienten mit Non-Hodgkin-Lymphomen in ein spezialisiertes Zentrum.
Durch die zunehmende Behandlung von Migranten ist mit einem vermehrten Auftreten von dort endemischen, spezifischen Krankheitsbildern zu rechnen.
OA Dr. Jan WolffSimon BurgProf. Dr. Dr. Martin GosauKlinik für Mund-, Kiefer-, und plastische Gesichtschirurgie, Klinikum NürnbergUniversitätsklinik der Paracelsus Medizinischen PrivatuniversitätBreslauerstraße 201, 90471 Nürnbergjan.wolff@klinikum-nuernberg.de
Dr. Volker MordsteinInstitut für Pathologie,Klinikum Nürnberg SüdBreslauer Straße 201, 90471 Nürnberg.
Literatur
Cairo, et al. Results of a randomized international study of high-risk central nervous system B non-Hodgkin lymphoma and B acute lymphoblastic leukemia in children and adolescents. Blood. 2007 Apr 1;109(7):2736-43
Giulino-Roth, et al., Recent molecular and therapeutic advances in B-cell non-Hodgkin lymphoma in children. Br J Haematol. 2016 May;173(4):531-44. doi: 10.1111/bjh.13969. Epub 2016 Mar 21.
Herold, et al. Innere Medizin. 2006, Seite 82
S1-LeitlinieNon-Hodgkin-Lymphome der Deutsche Krebsgesellschaft und Gesellschaft für Pädiatrische Onkologie und Hämatologie. In: AWMF online (Stand Januar 2009)
Salzburg et al., Prevalence, clinical pattern, and outcome of CNS involvement in childhood and adolescent non-Hodgkin's lymphoma differ by non-Hodgkin's lymphoma subtype: a Berlin-Frankfurt-Munster Group Report. J Clin Oncol. 2007 Sep 1;25(25):3915-22.
Woessmann, et al. The impact of the methotrexate administration schedule and dose in the treatment of children and adolescents with B-cell neoplasms: a report of the BFM Group Study NHL-BFM95. Blood. 2005 Feb 1;105(3):948-58. Epub 2004 Oct 14.